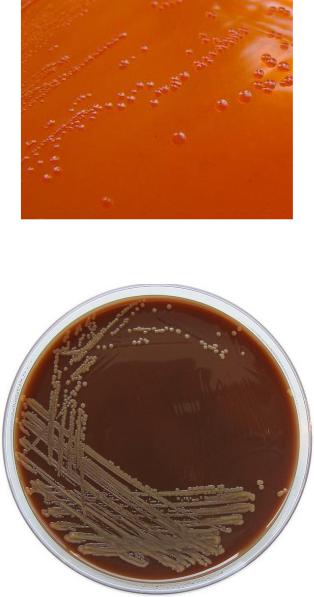

Материал: Нейссерии
6
температура роста 35-37°С, патогенные виды могут расти в интервале температур 24-41°С, а непатогенные виды способны к росту при температурах ниже 24°С. Оптимум рН 6-8. Патогенные виды прихотливы к условиям культивирования, не растут на обычных питательных средах; непатогенные виды менее прихотливы. Для выращивания патогенных нейссерий используют среды с кровью, сывороткой крови, многочисленными факторами роста (сывороточный агар, кровяной агар, шоколадный агар, среда Мак-Конки и др.). Культивирование проводят в атмосфере углекислого газа (5-7%). На плотных питательных средах через 24 часа нейссерии образуют нежные выпуклые круглые колонии с ровными краями. Виды, обитающие на слизистых оболочках верхних дыхательных путей, образуют желтый пигмент (рисунки 5 и 6).
Рисунок 5 - Рост N. subflava на агаре Мак-Конки.
Рисунок 6 - Рост N. subflava на колумбийском шоколадном агаре.
Ферментативная активность нейссерий низкая. Они продуцируют каталазу (за исключением Neisseria elongata) и цитохромоксидазу, ферментируют углеводы с образованием кислоты. Некоторые виды на среде с сахарозой образуют
7
полисахарид. Многие виды нейссерий редуцируют нитриты, некоторые восстанавливают нитраты. Отличительные признаки бактерий рода Neisseria представлены в таблице 1.
Таблица 1 - Основные дифференциально-диагностические свойства нейссерий
Вид |
|
|
|
|
|
Ферментация |
|
Образование полисахарида на среде с 5% сахарозы |
Редукция** |
|||
|
Рост на агаре без сыворотки |
2 |
|
|
|
|
|
|
|
|
|
|
|
Зависимость роста от СО |
Желтый пигмент |
глюкозы |
мальтоза |
|
сахароза |
фруктоза |
лактоза |
нитратов |
нитритов |
||
|
|
|
|
|
|
|
|
|
|
|
|
|
N. |
- |
+ |
- |
к |
- |
|
- |
- |
- |
- |
-**** |
-**** |
gonorrhoeae |
|
|
|
|
|
|
|
|
|
|
|
|
N. |
- |
+ |
- |
к |
к |
|
- |
- |
- |
- |
-**** |
-**** |
meningitidis |
|
|
|
|
|
|
|
|
|
|
|
|
N. subflava |
+/* |
- |
+ |
к |
к |
|
к/- |
к/- |
- |
-/+ |
- |
+ |
|
|
|
|
|
|
|
|
|
|
*** |
|
|
N. flava |
+/- |
- |
+ |
- |
- |
|
- |
- |
- |
+ |
- |
+ |
N. mucosa |
+ |
- |
+/- |
к |
к |
|
к |
к |
- |
+ |
+ |
+ |
N. sicca |
+/- |
- |
+/- |
к |
к |
|
к |
к |
- |
+ |
- |
+ |
N. lactamica |
+ |
- |
+ |
к |
к |
|
- |
- |
к |
- |
- |
+ |
Примечание:
*Биовар N. perflava не растет на бессывороточном агаре.
**Тест используется только для дифференциации условно-патогенных
нейссерий.
***Биовар N. perflava положителен.
****Некоторые штаммы редуцируют нитриты в низких концентрациях
(0,01%).
Антигенная структура. Все виды нейссерий имеют полисахаридный соматический О-антиген. Штаммы, образующие капсулу, также имеют капсульный антиген. В клеточной мембране патогенных нейссерий содержится нейссериальный поверхностный белок А (NspA).
Резистентность. Во внешней среде патогенные нейссерии не устойчивы. В связи с этим исследуемый материал доставляют в лабораторию в транспортных средах (транспортная среда для нейссерий, среда Эймса) в контейнерах, обеспечивающих температуру 30-35°С. Нейссерии чувствительны к действию многих антисептиков и дезинфектантов. Они обладают высокой чувствительностью к пенициллинам, тетрациклинам, стрептомицину. Однако в последнее время

8
получают распространение антибиотикоустойчивые штаммы нейссерий.
Менингококки
Менингококковая инфекция - это острое инфекционное заболевание человека, вызываемое Neisseria meningitidis и характеризующееся локальным поражением слизистой оболочки носоглотки с последующей генерализацией процесса в виде менингококковой септицемии (менингококцемии) и воспаления мягких мозговых оболочек (менингококкового менингита, эпидемического цереброспинального менингита).
Первые клинические описания менингококкового менингита представили английские врачи Т. Уиллис (Вилизий) и Т. Сиденхэм (рисунки 7 и 8).
Рисунок 7 - Томас Уиллис (Thomas Willis, 1621 – 1675 гг.).
Рисунок 8 - Томас Сиденхэм (Thomas Sydenham, 1624 – 1689 гг.).
Возбудитель менингита обнаружил в спинномозговой жидкости больного и детально описал в 1887 г. австрийский бактериолог А. Вайхзельбаум (рисунок 9).

9
Рисунок 9 - Aнтон Вайхзельбаум (A. Weichselbaum, 1845 – 1920 гг.).
Таксономия. Вид Neisseria meningitidis относится к семейству Neisseriaceae
роду Neisseria. В составе этого вида по капсульным полисахаридным антигенам выделяют более 13 серогрупп (A, B, C, D, X, Y, Z, W и др.). По белковым и полисахаридным антигенам клеточной стенки выделяют 20 сероваров или серотипов. Наиболее частыми возбудителями генерализованной менингококковой инфекции являются серогруппы A, B и C.
Морфологические и тинкториальные свойства. Менингококки имеют округлую форму диаметром 0,6-1,0 мкм, располагаются попарно. Поверхности, обращенные друг к другу, вогнутые или ровные (рисунок 10).
Рисунок 10 - Менингококки в препарате, компьютерная окраска.
Менингококки по Граму окрашиваются в красный цвет (грамотрицательные). В мазках часто наблюдается неравномерное окрашивание: молодые клетки окрашиваются интенсивно, а старые клетки воспринимают краситель очень слабо (рисунок 11).

10
Рисунок 11 - Чистая культура N. meningitidis. Окраска по Граму.
Менингококки имеют пили, не имеют жгутиков, спор не образуют. Выделенные из организма клетки образуют капсулу.
Культуральные свойства. Менингококки являются строгими аэробами и капнофилами. Они очень требовательны к условиям культивирования и хорошо растут в присутствии 5-7% углекислого газа. На простых питательных средах менингококки не растут, для их культивирования используют среды, содержащие кровь, сыворотку крови, яичный желток, аминокислоты, витамины. Оптимальное значение рН среды составляет 7,2-7,4. Оптимальная температура выращивания 37°С. На сывороточном агаре менингококки образуют полупрозрачные нежные колонии с ровными краями и блестящей поверхностью диаметром 0,5-1,5 мм (рисунок 12).
Рисунок 12 – Рост менингококков на сывороточном агаре.
На кровяном агаре формируются полупрозрачные сероватые колонии, гемолиз отсутствует (рисунок 13).